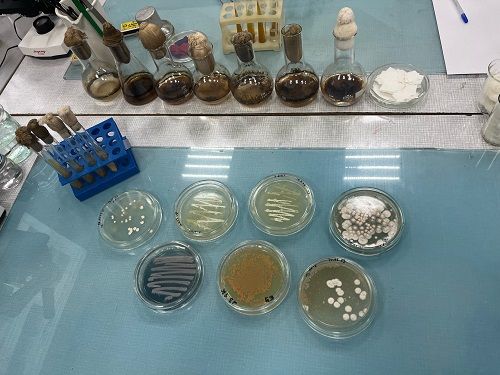

1 декабря 2023
28 ноября 2023 г. на кафедре микробиологии биолого-почвенного факультета проведен мастер-класс по профессии «Биоремедиатор» для учеников 11 класса СОШ № 53 г. Иркутска в рамках проекта по ранней профессиональной ориентации учащихся 9, 10, 11 классов общеобразовательных организаций «Билет в будущее».
Новой профессией микробиологического профиля является биоремедиатор. БИОРЕМЕДИАТОР – это специалист, вооруженный микробиологическими знаниями, который восстанавливает загрязненные экосистемы (почвы, водоемы и т. д.) с использованием микроорганизмов. Эта новая профессия с каждым годом будет становиться все более и более востребованной, поскольку очень остро стоит проблема очистки окружающей среды от разного рода загрязняющих веществ, наносящих вред природе, здоровью человека. Биоремедиатор призван разрабатывать технологии очистки окружающей среды от нефтепродуктов, тяжелых металлов, радионуклидов, пестицидов и других опасных загрязнителей. Одним из приоритетных направлений биоремедиации является ликвидация последствий загрязнений нефтью и нефтепродуктами при помощи микроорганизмов.
При проведении Профпробы учащиеся познакомились с разнообразием нефтеокисляющих микроорганизмов: бактериями, актиномицетами, дрожжами. Ребята научились делать различные микроскопические препараты, научились работать со световым микроскопом, воочию увидели клетки микроорганизмов, научились различать их морфологическое разнообразие. Учащиеся визуально оценили степень деструкции нефтяной пленки на поверхности среды в опытных колбах, сравнивая результаты с контролем (среда с нефтью в колбе, не засеянная микроорганизмами-нефтедеструкторами), охарактеризовали интенсивность роста микроорганизмов-нефтедеструкторов, и отобрали наиболее активные из них.